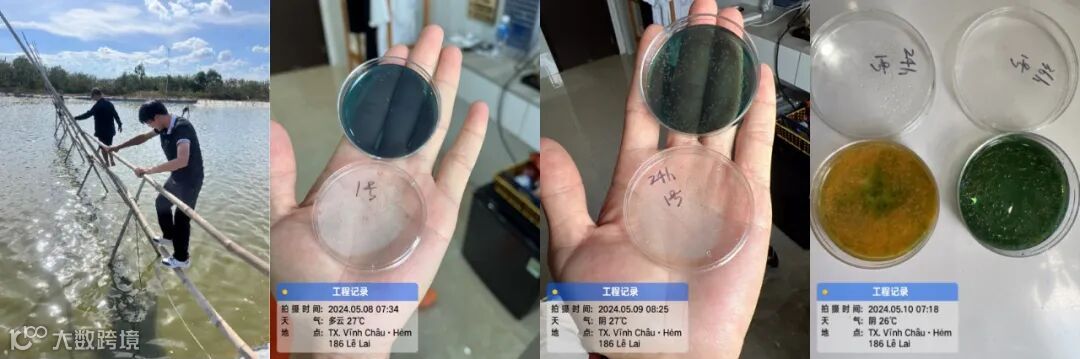

企业既是个人的,也是国家的,更是世界的。没有浩瀚的胸襟,就无法看到开阔的未来。没有分享的美德,成就不了伟大的企业。

优秀的技术,从来不担心被超越,只会加速我们的成长。优秀的产品,也从不担心被模仿,因为我们永远走在前面。如果一件事可以帮助更多的人,就应该让更多人知道。厦门昶科不断扩大自己的“朋友圈”,带着高质量产品走出国门。

从今年起,厦门昶科生物就开始布局越南市场,在当地建立了实验室,开展噬菌体、虾青素等研究实验,并验证了我们产品的使用效果已处于国际领先水平。不久之后,我们还会在越南正式成立海外分公司,把我们的品牌深入用户的心中。

信心是出海的通行证。厦门昶科积极进行全球化布局,不断提升深度和广度。一方面以优秀的预防和治疗效果帮助越南的养殖业增效降本;另一方面,扶持当地经济,吸纳人才,提升了品牌的认知度和影响力,更是展示我们民族企业的自信。

在曾经很长的一段时间里,中国企业还不够自信向世界展示我们的实力。但是如今,我们企业的技术、产品、服务已经可以比肩一流企业。我们以东南亚为支点,撬动我们的产品力,服务于全世界。





